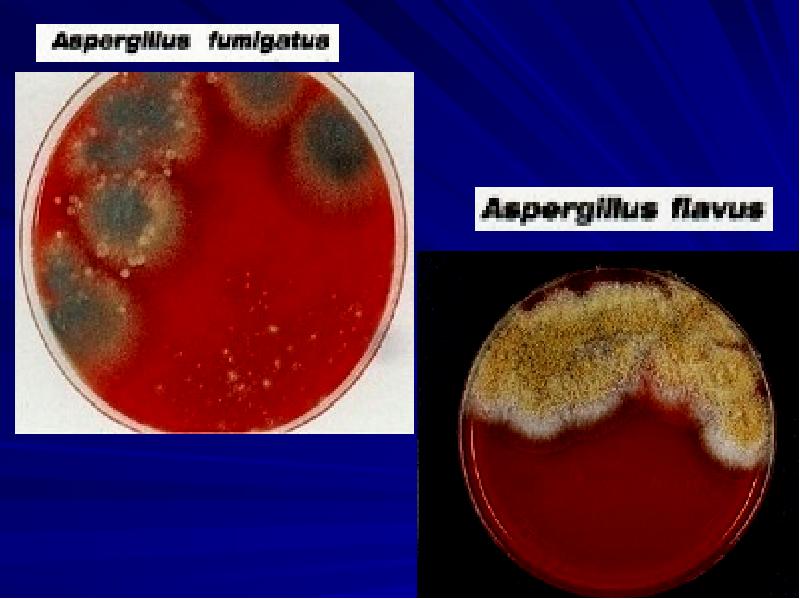

Микроскопические грибы презентация
Содержание
- 2. Из 70 тысяч видов микроскопических грибов около 300 - патогенны для
- 3. Общая характеристика Многоклеточные или одноклеточные микроорганизмы с признаками растений и животных
- 4. В основу систематики грибов положено большое разнообразие способов и органов их
- 5. Царство: Mycota (Fungi) Отряд: Mycomycota Eumycota Классы грибов:
- 7. Морфология Клетки гриба окружены многослойной ригидной клеточной стенкой и ЦПМ.
- 9. Морфологические формы Диморфизм Гифальная (плесневые грибы) Клетки гриба- гифы, тонкие
- 10. Гифы высших грибов разделены перегородками (септами), которые имеют поры. Гифы низших
- 12. Дрожжевая форма Дрожжевая форма Клетки грибов имеют округлую форму, образуют псевдогифы,
- 13. Грибы подобные дрожжам и не имеющие полового размножения называют дрожжеподобными. Грибы
- 14. Способность к гифальному или дрожжевому росту зависит от условий культивирования (температуры
- 16. Резистентность Грибы устойчивы к действию физических и химических факторов. Прямой солнечный
- 17. Размножение Половое (гаметы, половые споры) бесполое (бесполые споры) вегетативное (фрагментация,
- 18. Половые формы гриба получили название- телеморфы. Бесполые формы грибов назвали анаморфами.
- 19. Спорообразующие структуры грибов называются спорофорами. Спорообразующие структуры грибов называются спорофорами. Терминальный
- 20. Спорофоры, формирующие свободные споры, называются конидиефорами (или конидиеносцами), а свободные споры называются экзоспорами или конидиями.
- 22. Для некоторых видов грибов характерно тесное сплетение нескольких конидиеносцев в пучок.
- 23. Типы экзогенных спор: Артроконидии образуются путем равномерного септирования и расчленения
- 24. У некоторых грибов для размножения служат: склероции – твердые образования из
- 25. Склероции имеют толстую, плотную оболочку (толстостенные и тёмные клетки) и сердцевину
- 26. В большинстве случаев склероций состоит исключительно из грибных гиф, Некоторые
- 29. Бесполые споры образуются при благоприятных условиях и служат для распространения вида.
- 30. Половые споры образуются в результате слияния двух клеток. Слияние может быть
- 31. Зигоспоры- верхушки близко расположенных гиф сливаются, в результате мейоза образуются крупные
- 32. Базидиоспоры являются органами полового спороношения. Базидиоспоры являются органами полового спороношения. Происходит
- 33. Типы базидий: Холобазидии имеют булавовидную форму и одноклеточное строение. Гетеробазидии состоят из
- 35. Класс Хитридиомицеты (греч. капелька). Архимицеты. Одноклеточные грибы, преимущественно водные. Около 500
- 36. Зачаточный мицелий, клетки в виде протопластов с несколькими ядрами. Зачаточный
- 37. Класс Зигомицеты [от греч. zygon, сочленение, + mykes, гриб] объединяет
- 38. зигомицеты Низшие грибы, размножение половое и бесполое. При половом размножении образуются
- 39. зигомицеты Представители родов: Rhizopus, Mucor, Rhizomucor, Absidia, Conidiobolus и др.
- 40. Мицелий зигомицетов имеет два знака («+» и «-»). При контакте противоположных
- 41. Зигомицеты вегетативно распространяются столонами — выбрасываемыми в воздушную среду длинными гифами, которые
- 42. Некоторые зигомицеты способны вызывать вторичные инфекции человека. Тропические роды могут вызывать грануломатоз.
- 43. Используются как продуценты различных веществ. Используются как продуценты различных веществ. Rhizopus
- 44. Класс Аскомицеты [от греч. askos, сумка, + mykes, гриб] 30 000
- 45. Аскомицеты Представители родов: Saccharomyces, Arthroderma, Aspergills, Penicillium, Fusarium и др.
- 47. В зависимости от места расположения сумок и характера их образования выделяют
- 50. Класс Дейтеромицеты [от греч. deuteros, вторичный, + mykes, гриб] формальная группа
- 51. Deuteromycetes имеют многоклеточный, хорошо развитый мицелий. Deuteromycetes имеют многоклеточный, хорошо
- 53. У многих представителей в цикле их развития формируются две конидиальные стадии (например, макроконидии и
- 54. Многие дейтеромицеты образуют конидиеносцы, объединенные в группы на мицелии или внутри пикнид. Простейшая форма такой аггрегации конидиеносцев - коремии.
- 55. Большая часть возбудителей микозов человека входит в группу несовершенных грибов.
- 56. Дейтеромицеты представители родов: Cryptococcus, Malassezia, Coccidioides, Sporpthrix, Fonsecaea и др.
- 57. Класс Базидиомицеты [от греч. basidon, маленькая основа, + mykes, гриб]
- 58. В морфологии базидий выделяют три основные части: В морфологии базидий выделяют
- 60. Мицелий базидиомицетов септирован, каждая клетка содержит по 2 гаплоидных ядра. Мицелий базидиомицетов септирован, каждая клетка содержит по
- 62. Единственным облигатным патогенном для человека выступает Filobasidiella neoformans (половая форма Cryptococcus
- 63. Культивирование грибов Грибы – гетеротрофы и нуждаются в дополнительных факторах роста,
- 68. Факторы патогенности микроскопических грибов Токсические морфологические компоненты (полисахариды и липиды грибов);
- 69. Важную роль на патогенез любых микозов оказывают нарушения обмена веществ и
- 70. Выделяют микозы: Первичные- вызывают облигатно патогенные грибы (Histoplasma capsulatum, Coccidioides immitis
- 71. Возбудители системных или глубоких микозов (возбудители кокцидиоидоза, гистоплазмоза, криптококкоза, бластомикоза); Возбудители
- 72. Лабораторная диагностика микозов Микроскопический- исследуют патологический материал- чешуйки кожи, волосы размягченные
- 74. Окончательное заключение делают после микологического исследования. Посевы инкубируют при температуре 25оС
- 75. Серологическое исследование. При серологическом исследовании обнаруживают уже через 2-4 недели
- 76. Биологический метод- для выделения гриба используют внутрибрюшинное, подкожное и интратестикулярное заражение
- 77. Антимикотики Азолы - нарушают синтез эргостерола (кетоконазол, миконазол, клотримазол, дифлюкан) Алиламины
- 79. Возбудители микотоксикозов Микотоксикозы- заболевания обусловленные попаданием в организм токсинов грибов.
- 80. Классы микотоксинов Афлотоксины (spp.Aspergillus) Трихотецены (spp. Fusarium) Охратоксины (spp. Aspergillus, spp.
- 81. Афлотоксикозы Aspergillus fumigatus Aspergillus flavus Грибы развиваются на злаках (рис, кукуруза,
- 82. По химической природе- производные кумарина По химической природе- производные кумарина Афлотоксин
- 83. Охратоксины Образуются грибами рода Fusarium, Penicillum в диапазоне температур от 0
- 84. Трихотецены Грибы: Fusarium sporotrichiella, Fusarium graminearum, Fusarium nivaie Развиваются на злаковых
- 85. Известно более 40 токсинов данной группы. Наибольшее значение имеют Т-2 и
- 86. Эрготоксины Claviceps paspali, Claviceps purpurae Производные лизоргиновой кислоты и клавиновые алкалоиды.
- 87. Патуллотоксины Продуцируются грибами рода Penicillum при развитии на пищевых продуктах, варенье,
- 88. Благодарим за внимание!
- 89. Скачать презентацию




































![Класс Зигомицеты
[от греч. zygon, сочленение, + mykes, гриб]
Класс Зигомицеты
[от греч. zygon, сочленение, + mykes, гриб]](/documents_3/2ce63d652313d6b3c971d6be299572ef/img36.jpg)






![Класс Аскомицеты
[от греч. askos, сумка, + mykes, гриб] 30 Класс Аскомицеты
[от греч. askos, сумка, + mykes, гриб] 30](/documents_3/2ce63d652313d6b3c971d6be299572ef/img43.jpg)





![Класс Дейтеромицеты
[от греч. deuteros, вторичный, + mykes, гриб] формальная Класс Дейтеромицеты
[от греч. deuteros, вторичный, + mykes, гриб] формальная](/documents_3/2ce63d652313d6b3c971d6be299572ef/img49.jpg)






![Класс Базидиомицеты
[от греч. basidon, маленькая основа, + mykes, гриб]
Класс Базидиомицеты
[от греч. basidon, маленькая основа, + mykes, гриб]](/documents_3/2ce63d652313d6b3c971d6be299572ef/img56.jpg)

Слайды и текст этой презентации
Похожие презентации